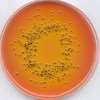

产品目录
-
-
-
-
-
IQ7003\7005\7010\7015 IQ 7000 EQ7000 Milli-Q Direct 8/16 EQ7008/7016 Synergy Direct-Q3/5/8 Elix® Essential 3/5/10/15 Reference Milli-Q Integral 3/5/10/15 Advantage A10 IX 7003\7005\7010\7015 明澈(MING CHE) Simplicity IQ Element Elix Advantage 3/5/10/15 RiOs™ Essential 3/5/10/15 RiOs-DI® RiOs™ 3/5/8 Milli-DI 3 Direct-Q8 其他水机耗材配件
-
-
-
-
-
-
-
-